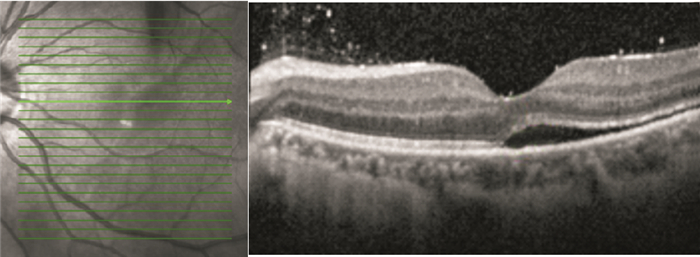

引用本文: 孟旭霞, 周賢慧, 劉鵬輝. 累及黃斑的孔源性視網膜脫離鞏膜扣帶手術后視網膜形態與視功能恢復的觀察. 中華眼底病雜志, 2014, 30(4): 348-351. doi: 10.3760/cma.j.issn.1005-1015.2014.04.004 復制
鞏膜扣帶手術后視功能評估主要依賴于視力及光相干斷層掃描(OCT)檢查結果。OCT因其高分辨率、無創且可直觀觀察黃斑區微結構形態,但對視網膜周邊結構的觀察存在局限性[1]。視野相對于中心視銳度,主要反映周邊視野改變。視野平均缺損(MD)是受檢眼光敏感度與同年齡正常人光敏感度之差的平均值,主要反應全視網膜光敏感度是否下降及下降的程度,受變異的影響較小;丟失方差(LV)是視野形狀與正常視野形狀的相差程度,主要反映局部視野的缺損。為此,我們采用OCT聯合視野檢查對一組累及黃斑的孔源性視網膜脫離患者鞏膜扣帶手術后的視網膜形態與視功能進行了觀察。現將結果報告如下。
1 對象和方法
前瞻性臨床研究。2011年1月至2012年12月在我院行鞏膜扣帶手術治療的累及黃斑的孔源性視網膜脫離的連續性病例41例42只眼納入研究。其中,男性26例27只眼,占64.29%;女性15例15只眼,占35.71%。年齡18~65歲,平均年齡(33.78±11.21)歲。納入標準:非復雜性孔源性視網膜脫離累及黃斑,裂孔直徑<4個視盤直徑者。排除標準:屈光度>6.0 D;既往有黃斑病變;黃斑裂孔;屈光間質混濁影響手術中觀察裂孔者;理解能力差,不能配合檢查者。患眼中,近視者15只眼;有明確外傷史者21只眼;其他6只眼。均行最佳矯正視力(BCVA)、眼壓、雙目間接檢眼鏡、電腦視野、OCT、B型超聲檢查。BCVA檢查采用Snellen視力表,小數記錄。OCT檢查采用德國海德堡Spectralis OCT儀。視野檢查采用瑞士Haag-Streit公司Octopus 900視野計。
患眼BCVA 0.02~0.6,平均BCVA 0.29±0.18。視網膜脫離時間2~180 d,平均脫離時間(21.12±3.71) d。OCT檢查見視網膜脫離均累及黃斑區,可見視網膜下液。MD值8.5~25.5 dB,平均MD值(13.54±6.44) dB;LV值11.0~5.8 dB,平均LV值(8.43±2.11) dB。
所有患者知情并簽署手術同意書后行鞏膜扣帶手術,所有手術由同一醫師完成。手術前雙目間接檢眼鏡聯合B型超聲檢查確定視網膜裂孔位置、數目、脫離范圍,并據此選擇手術方式。其中,行外墊壓手術29只眼;聯合環扎手術13只眼。外墊壓手術時,手術中沿角鞏膜緣打開視網膜脫離區域的球結膜,鈍性分離出相應的直肌,放置大小適宜的墊壓嵴;聯合行環扎手術時,充分暴露4條直肌,放置環扎帶并固定。所有患者均行視網膜放液,鞏膜外冷凍。手術結束時給予地塞米松5 mg球旁注射,氧氟沙星眼膏涂眼、包扎。手術后第1天開始給予妥布霉素地塞米松滴眼液點眼,4次/d,連續1個月。
手術后隨訪6~24個月,平均隨訪時間(12.41±5.22)個月。手術后1、2周,1、3、6、12個月采用與手術前相同的設備和方法行相關檢查。觀察BCVA、視野和視網膜形態的變化;手術后12個月各組BCVA恢復情況。雙目間接檢眼鏡聯合B型超聲、OCT檢查觀察視網膜下液吸收時間。
采用SPSS 16.0統計軟件進行統計學分析處理。計量資料采用均數±標準差(
2 結果
所有患眼均為一次手術后視網膜復位,無復發性視網膜脫離者。雙目間接檢眼鏡聯合B型超聲檢查發現,手術后視網膜下液吸收,視網膜復位時間3~10 d,平均復位時間(7.32±2.53) d。其中,7 d內復位者40只眼,占95.2%;10 d復位者2只眼,占4.8%。
OCT檢查發現,手術后視網膜下液吸收時間1~13個月,平均視網膜下液吸收時間(7.82±3.52)個月。手術后12個月,42只眼中,視網膜下液吸收37只眼,占88.1%;視網膜下液殘留5只眼,占11.9%。視網膜下液吸收37只眼中,視網膜微結構正常15只眼;神經上皮層黃斑囊樣水腫5只眼(圖 1);光感受器內外節連接(IS/OS)斷裂12只眼;IS/OS和外界膜(ELM)斷裂5只眼(圖 2)。
 圖1
患眼OCT像。神經上皮層黃斑囊樣水腫
圖1
患眼OCT像。神經上皮層黃斑囊樣水腫
 圖2
患眼OCT像。IS/OS聯合ELM斷裂
圖2
患眼OCT像。IS/OS聯合ELM斷裂
手術后1、3、6、12個月,BCVA 1.0者分別為1、8、11、15只眼。手術后6個月BCVA 0.15~1.0,平均BCVA0.59±0.29;手術后12個月,BCVA 0.15~1.0,平均BCVA 0.65±0.28。手術后6、12個月平均BCVA比較,差異無統計學意義(t=-0.636, P=0.529)。手術后12個月,視網膜下液吸收者BCVA 0.3~1.0,平均BCVA 0.68±0.34。其中,視網膜微結構正常者0.86±0.14;神經上皮層黃斑囊樣水腫者0.52±0.12;IS/OS斷裂者0.55±0.08;IS/OS和ELM斷裂者0.44±0.11。視網膜下液殘留者BCVA 0.15~1.0,平均BCVA 0.57±0.40,其中,BCVA 1.0者2只眼(圖 3)。視網膜微結構正常者、神經上皮層黃斑囊樣水腫者、IS/OS斷裂者、IS/OS和ELM斷裂者之間平均BCVA比較,差異有統計學意義(F=52.42,P<0.05)。視網膜下液殘留者平均BCVA與視網膜下液吸收者之間比較,差異有統計學意義(t=-5.747, P=0.000)。
 圖3
患眼手術后6個月OCT像。視網膜下仍存在積液
圖3
患眼手術后6個月OCT像。視網膜下仍存在積液
手術后1、2周,1、3、6、12個月,平均MD值分別為(11.38±2.53)、(10.14±2.19)、(9.17±2.13)、(6.63±1.70)、(5.71±1.89)、(5.14±1.69)dB。各觀察時間點平均MD值比較,差異有統計學意義(F=63.528,P=0.00)。手術后6、12個月平均MD值比較,差異無統計學意義(t=1.442,P=0.157)。手術后12個月,MD值恢復正常12只眼;偏高30只眼。MD值偏高的30只眼與對側眼MD值比較,差異無統計學意義(t=-1.936,P=0.06)。視網膜微結構恢復正常15只眼中,MD值偏高6只眼。相關性分析結果顯示,視網膜微結構正常者平均MD值與手術前視網膜脫離時間呈正相關,差異有統計學意義(r=0.84, P=0.00),并且視野缺損多位于裂孔區(圖 4)。
 圖4
患眼手術后6個月視野檢查圖。鼻上方裂孔區域仍有視野缺損
圖4
患眼手術后6個月視野檢查圖。鼻上方裂孔區域仍有視野缺損
手術后1、2周,1、3、6、12個月平均LV值分別為(7.88±2.28)、(6.98±1.84)、(6.45±2.38)、(5.01±1.89)、(3.88±2.30)、(3.26±1.72)dB。各觀察時間點平均LV值比較,差異有統計學意義(F=57.25,P=0.00)。
3 討論
本組患者手術后2周,雙目檢眼鏡聯合B型超聲檢查見視網膜復位;OCT檢查提示視網膜下仍有部分積液,直至手術后12個月,視網膜復位率亦未達到100%。分析其主要原因,OCT分辨率較B型超聲高近10倍,可獲得10 μm的高分辨率,能更清楚的顯示視網膜各層結構,發現微小異常。手術后12個月OCT檢查示視網膜下液吸收率為88.1%,與Wolfensberger和Gonvers[2]報道的手術后1年11.0%的患者殘存黃斑下積液的發生率相當。有文獻報道,影響視力預后的主要因素有視網膜脫離時間、神經上皮層囊樣水腫、視網膜下液殘留、IS/OS損傷及ELM破壞[3]。視網膜脫離時間影響手術后視力的恢復已成為共識[1, 4, 5],但黃斑積液對視力的影響尚無定論[6]。Wakabayashi等[7]認為黃斑積液對手術后視力無明顯影響,而本組患者手術后12個月,黃斑處視網膜積液明顯影響手術后視力。其原因主要是黃斑下積液導致視網膜神經層和視網膜色素上皮(RPE)層之間的物質轉運發生障礙。及時發現并手術,視力預后較好;積液時間過長,光感受器細胞外節的代謝受影響,視力預后差。
光感受器細胞IS/OS連續及ELM完整,是實現正常視覺的重要條件[8]。惠延年[9]認為視網膜脫離復位后,隨著IS/OS修復,視力逐漸恢復。而當IS/OS聯合ELM受損時則預示著這種損害擴展到細胞體及Müller細胞。因ELM較IS/OS更靠近細胞核,ELM受損代表光感受器細胞損傷加重,并且已有研究表明,單純IS/OS斷裂可以自行恢復,而聯合ELM受損后,IS/OS不能恢復[10, 11],表明ELM損傷對在IS/OS損傷修復中的作用,并且側面反映出ELM損傷對IS/OS的影響。本研究IS/OS斷裂12只眼中,聯合ELM破壞5只眼,印證了Delolme等[12]觀察的IS/OS受損多聯合ELM損傷的觀點。
視野相對于中心視銳度而言,它主要反映了周邊視野。MD是反應全視網膜光敏感度是否下降及下降的程度,受變異的影響較小,有利于對患者的隨訪。本研究通過對手術前后MD觀察發現,累及黃斑的視網膜脫離手術后MD逐漸減小;至手術后6個月視網膜缺損處于穩定狀態,與手術后12個月MD值比較,差異無統計學意義。本研究結果顯示,即使OCT檢查視網膜微結構正常的15只眼中,仍有6只眼視野未恢復正常,且未恢復的缺損區多位于視網膜裂孔處。我們認為此種情況與患者視網膜脫離時間較長有關。本組患者視網膜脫離時間平均為(21.12±3.71) d,而有研究發現,視網膜脫離12 h,細胞即出現凋亡,且以前3 d為著。隨著視網膜脫離時間延長,視網膜下液積存,視網膜缺乏脈絡膜層的血液供應,光感受器和RPE層間的物質轉運障礙,即使手術后視網膜解剖復位,視網膜光感受器細胞層功能受損難以恢復,影響視野預后。LV是視野形狀與正常視野形狀的相差程度,主要反映局部視野的缺損[13]。本研究中,患眼LV手術后逐漸減小,前6個月變化較快,至手術后12個月尚有19只眼未恢復正常,可能與MD變化有關。
本組患眼中,有2只眼BCVA 1.0,但OCT檢查見視網膜下液殘留。對此目前尚無明確的解釋。需擴大樣本量并進一步完善相關檢查后,有望對此現象進行解釋。
鞏膜扣帶手術后視功能評估主要依賴于視力及光相干斷層掃描(OCT)檢查結果。OCT因其高分辨率、無創且可直觀觀察黃斑區微結構形態,但對視網膜周邊結構的觀察存在局限性[1]。視野相對于中心視銳度,主要反映周邊視野改變。視野平均缺損(MD)是受檢眼光敏感度與同年齡正常人光敏感度之差的平均值,主要反應全視網膜光敏感度是否下降及下降的程度,受變異的影響較小;丟失方差(LV)是視野形狀與正常視野形狀的相差程度,主要反映局部視野的缺損。為此,我們采用OCT聯合視野檢查對一組累及黃斑的孔源性視網膜脫離患者鞏膜扣帶手術后的視網膜形態與視功能進行了觀察。現將結果報告如下。
1 對象和方法
前瞻性臨床研究。2011年1月至2012年12月在我院行鞏膜扣帶手術治療的累及黃斑的孔源性視網膜脫離的連續性病例41例42只眼納入研究。其中,男性26例27只眼,占64.29%;女性15例15只眼,占35.71%。年齡18~65歲,平均年齡(33.78±11.21)歲。納入標準:非復雜性孔源性視網膜脫離累及黃斑,裂孔直徑<4個視盤直徑者。排除標準:屈光度>6.0 D;既往有黃斑病變;黃斑裂孔;屈光間質混濁影響手術中觀察裂孔者;理解能力差,不能配合檢查者。患眼中,近視者15只眼;有明確外傷史者21只眼;其他6只眼。均行最佳矯正視力(BCVA)、眼壓、雙目間接檢眼鏡、電腦視野、OCT、B型超聲檢查。BCVA檢查采用Snellen視力表,小數記錄。OCT檢查采用德國海德堡Spectralis OCT儀。視野檢查采用瑞士Haag-Streit公司Octopus 900視野計。
患眼BCVA 0.02~0.6,平均BCVA 0.29±0.18。視網膜脫離時間2~180 d,平均脫離時間(21.12±3.71) d。OCT檢查見視網膜脫離均累及黃斑區,可見視網膜下液。MD值8.5~25.5 dB,平均MD值(13.54±6.44) dB;LV值11.0~5.8 dB,平均LV值(8.43±2.11) dB。
所有患者知情并簽署手術同意書后行鞏膜扣帶手術,所有手術由同一醫師完成。手術前雙目間接檢眼鏡聯合B型超聲檢查確定視網膜裂孔位置、數目、脫離范圍,并據此選擇手術方式。其中,行外墊壓手術29只眼;聯合環扎手術13只眼。外墊壓手術時,手術中沿角鞏膜緣打開視網膜脫離區域的球結膜,鈍性分離出相應的直肌,放置大小適宜的墊壓嵴;聯合行環扎手術時,充分暴露4條直肌,放置環扎帶并固定。所有患者均行視網膜放液,鞏膜外冷凍。手術結束時給予地塞米松5 mg球旁注射,氧氟沙星眼膏涂眼、包扎。手術后第1天開始給予妥布霉素地塞米松滴眼液點眼,4次/d,連續1個月。
手術后隨訪6~24個月,平均隨訪時間(12.41±5.22)個月。手術后1、2周,1、3、6、12個月采用與手術前相同的設備和方法行相關檢查。觀察BCVA、視野和視網膜形態的變化;手術后12個月各組BCVA恢復情況。雙目間接檢眼鏡聯合B型超聲、OCT檢查觀察視網膜下液吸收時間。
采用SPSS 16.0統計軟件進行統計學分析處理。計量資料采用均數±標準差(
2 結果
所有患眼均為一次手術后視網膜復位,無復發性視網膜脫離者。雙目間接檢眼鏡聯合B型超聲檢查發現,手術后視網膜下液吸收,視網膜復位時間3~10 d,平均復位時間(7.32±2.53) d。其中,7 d內復位者40只眼,占95.2%;10 d復位者2只眼,占4.8%。
OCT檢查發現,手術后視網膜下液吸收時間1~13個月,平均視網膜下液吸收時間(7.82±3.52)個月。手術后12個月,42只眼中,視網膜下液吸收37只眼,占88.1%;視網膜下液殘留5只眼,占11.9%。視網膜下液吸收37只眼中,視網膜微結構正常15只眼;神經上皮層黃斑囊樣水腫5只眼(圖 1);光感受器內外節連接(IS/OS)斷裂12只眼;IS/OS和外界膜(ELM)斷裂5只眼(圖 2)。
 圖1
患眼OCT像。神經上皮層黃斑囊樣水腫
圖1
患眼OCT像。神經上皮層黃斑囊樣水腫
 圖2
患眼OCT像。IS/OS聯合ELM斷裂
圖2
患眼OCT像。IS/OS聯合ELM斷裂
手術后1、3、6、12個月,BCVA 1.0者分別為1、8、11、15只眼。手術后6個月BCVA 0.15~1.0,平均BCVA0.59±0.29;手術后12個月,BCVA 0.15~1.0,平均BCVA 0.65±0.28。手術后6、12個月平均BCVA比較,差異無統計學意義(t=-0.636, P=0.529)。手術后12個月,視網膜下液吸收者BCVA 0.3~1.0,平均BCVA 0.68±0.34。其中,視網膜微結構正常者0.86±0.14;神經上皮層黃斑囊樣水腫者0.52±0.12;IS/OS斷裂者0.55±0.08;IS/OS和ELM斷裂者0.44±0.11。視網膜下液殘留者BCVA 0.15~1.0,平均BCVA 0.57±0.40,其中,BCVA 1.0者2只眼(圖 3)。視網膜微結構正常者、神經上皮層黃斑囊樣水腫者、IS/OS斷裂者、IS/OS和ELM斷裂者之間平均BCVA比較,差異有統計學意義(F=52.42,P<0.05)。視網膜下液殘留者平均BCVA與視網膜下液吸收者之間比較,差異有統計學意義(t=-5.747, P=0.000)。
 圖3
患眼手術后6個月OCT像。視網膜下仍存在積液
圖3
患眼手術后6個月OCT像。視網膜下仍存在積液
手術后1、2周,1、3、6、12個月,平均MD值分別為(11.38±2.53)、(10.14±2.19)、(9.17±2.13)、(6.63±1.70)、(5.71±1.89)、(5.14±1.69)dB。各觀察時間點平均MD值比較,差異有統計學意義(F=63.528,P=0.00)。手術后6、12個月平均MD值比較,差異無統計學意義(t=1.442,P=0.157)。手術后12個月,MD值恢復正常12只眼;偏高30只眼。MD值偏高的30只眼與對側眼MD值比較,差異無統計學意義(t=-1.936,P=0.06)。視網膜微結構恢復正常15只眼中,MD值偏高6只眼。相關性分析結果顯示,視網膜微結構正常者平均MD值與手術前視網膜脫離時間呈正相關,差異有統計學意義(r=0.84, P=0.00),并且視野缺損多位于裂孔區(圖 4)。
 圖4
患眼手術后6個月視野檢查圖。鼻上方裂孔區域仍有視野缺損
圖4
患眼手術后6個月視野檢查圖。鼻上方裂孔區域仍有視野缺損
手術后1、2周,1、3、6、12個月平均LV值分別為(7.88±2.28)、(6.98±1.84)、(6.45±2.38)、(5.01±1.89)、(3.88±2.30)、(3.26±1.72)dB。各觀察時間點平均LV值比較,差異有統計學意義(F=57.25,P=0.00)。
3 討論
本組患者手術后2周,雙目檢眼鏡聯合B型超聲檢查見視網膜復位;OCT檢查提示視網膜下仍有部分積液,直至手術后12個月,視網膜復位率亦未達到100%。分析其主要原因,OCT分辨率較B型超聲高近10倍,可獲得10 μm的高分辨率,能更清楚的顯示視網膜各層結構,發現微小異常。手術后12個月OCT檢查示視網膜下液吸收率為88.1%,與Wolfensberger和Gonvers[2]報道的手術后1年11.0%的患者殘存黃斑下積液的發生率相當。有文獻報道,影響視力預后的主要因素有視網膜脫離時間、神經上皮層囊樣水腫、視網膜下液殘留、IS/OS損傷及ELM破壞[3]。視網膜脫離時間影響手術后視力的恢復已成為共識[1, 4, 5],但黃斑積液對視力的影響尚無定論[6]。Wakabayashi等[7]認為黃斑積液對手術后視力無明顯影響,而本組患者手術后12個月,黃斑處視網膜積液明顯影響手術后視力。其原因主要是黃斑下積液導致視網膜神經層和視網膜色素上皮(RPE)層之間的物質轉運發生障礙。及時發現并手術,視力預后較好;積液時間過長,光感受器細胞外節的代謝受影響,視力預后差。
光感受器細胞IS/OS連續及ELM完整,是實現正常視覺的重要條件[8]。惠延年[9]認為視網膜脫離復位后,隨著IS/OS修復,視力逐漸恢復。而當IS/OS聯合ELM受損時則預示著這種損害擴展到細胞體及Müller細胞。因ELM較IS/OS更靠近細胞核,ELM受損代表光感受器細胞損傷加重,并且已有研究表明,單純IS/OS斷裂可以自行恢復,而聯合ELM受損后,IS/OS不能恢復[10, 11],表明ELM損傷對在IS/OS損傷修復中的作用,并且側面反映出ELM損傷對IS/OS的影響。本研究IS/OS斷裂12只眼中,聯合ELM破壞5只眼,印證了Delolme等[12]觀察的IS/OS受損多聯合ELM損傷的觀點。
視野相對于中心視銳度而言,它主要反映了周邊視野。MD是反應全視網膜光敏感度是否下降及下降的程度,受變異的影響較小,有利于對患者的隨訪。本研究通過對手術前后MD觀察發現,累及黃斑的視網膜脫離手術后MD逐漸減小;至手術后6個月視網膜缺損處于穩定狀態,與手術后12個月MD值比較,差異無統計學意義。本研究結果顯示,即使OCT檢查視網膜微結構正常的15只眼中,仍有6只眼視野未恢復正常,且未恢復的缺損區多位于視網膜裂孔處。我們認為此種情況與患者視網膜脫離時間較長有關。本組患者視網膜脫離時間平均為(21.12±3.71) d,而有研究發現,視網膜脫離12 h,細胞即出現凋亡,且以前3 d為著。隨著視網膜脫離時間延長,視網膜下液積存,視網膜缺乏脈絡膜層的血液供應,光感受器和RPE層間的物質轉運障礙,即使手術后視網膜解剖復位,視網膜光感受器細胞層功能受損難以恢復,影響視野預后。LV是視野形狀與正常視野形狀的相差程度,主要反映局部視野的缺損[13]。本研究中,患眼LV手術后逐漸減小,前6個月變化較快,至手術后12個月尚有19只眼未恢復正常,可能與MD變化有關。
本組患眼中,有2只眼BCVA 1.0,但OCT檢查見視網膜下液殘留。對此目前尚無明確的解釋。需擴大樣本量并進一步完善相關檢查后,有望對此現象進行解釋。